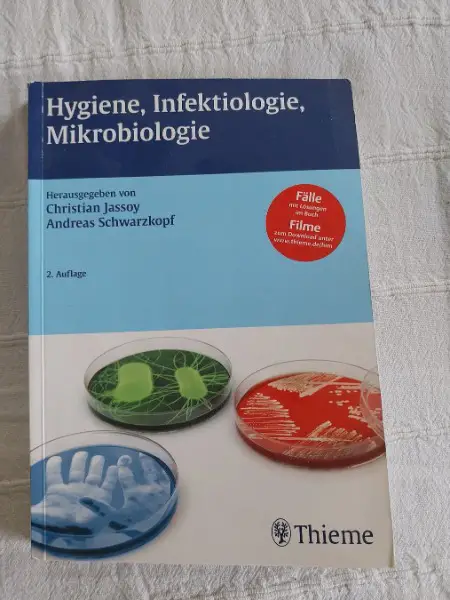
Hygiene, Infektiologie, Mikrobiologie Christian Jassoy, And

leichte Gebrauchsspuren Paket B-Post, CHF 8.50

siehe Bilder, sieht gut aus wiegt über 1,1kg Paket B-Post, CHF 8.50

leichte Gebrauchsspuren Brief B-Post, CHF 2.50

Angeboten wir ein frisch geschnittener Kopfsteckling. Dieser beinhaltet die 3 Blätter die einzeln photographiert worden sind. Geschnitten wird unter dem Luftwurzelkranz. Ich möchte sie nicht so gerne versenden, die weissen Blätter sind empfindlich.

siehe Bilder, 2 Bezüge Decke wiegt mit Bezug in einem leichten Wäschekorb 11,1kg Die mit Glasperlen gefüllte Baumwolldecke (Innen) sowie dem kuschelweichen Minkyfleece Bezug (Aussen) . Die kleinen, geräuschlosen Glasperlen sind in rechteckige Quadrate im Innenbezug eingenäht. Tier- und Rauchfreier Haushalt

Wird frisch geschnitten bei Abholung oder Versand. Lässt sich sehr gut und schnell im Wasser bewurzeln. Paket A-Post, CHF 11.50

siehe Bilder Hat bis zum Schluss alles funktioniert nur Abholung

Ich möchte die Pflanzen teilen. Angeboten wird die Hälfte des Topfinhaltes. Die Seite mit der Blüte bleibt bei mir. Sie steht bis jetzt noch im Garten, kommt jetzt in den Wintergarten und dann in die Wohnung. Paket A-Post, CHF 12.00

Ein-, zweimal gebraucht. Paket B-Post, CHF 8.50

geöffnet um dann festzustellen, das wir einen anderen "Nippel* brauchen Brief B-Post, CHF 3.00

Nur komplett, es hat alles bis zum Schluss funktioniert.

Angeboten wird 1 massiver Kleiderständer aus Holz in schwerer Qualität, handgefertigt von einem Schreiner. Material: massives Holz und schwere Eisenstangen. Gut geeignet für z.B. Keller, Lager oder gewerbliche Zwecke, Vereine .... Masse: 186 cm hoch, 150 cm breit, 70 cm tief Wir haben von der Sorte 2Stk. können aber nur einen gebrauchen. Der zweite ist auseina...

neu 1Stk. 14CHF - 3Stk. 40CHF Paket B-Post, CHF 8.50

sieht wie neu aus 500g 2,5cm dick Paket B-Post, CHF 8.50

Dieter Martinetz, Karlheinz Lohs: Gift: Magie u. Realität, Nutzen und Verderben 650g 1,9cm leichte Gebrauchsspuren Paket B-Post, CHF 8.50

Siehe Bild Paket B-Post, CHF 8.50